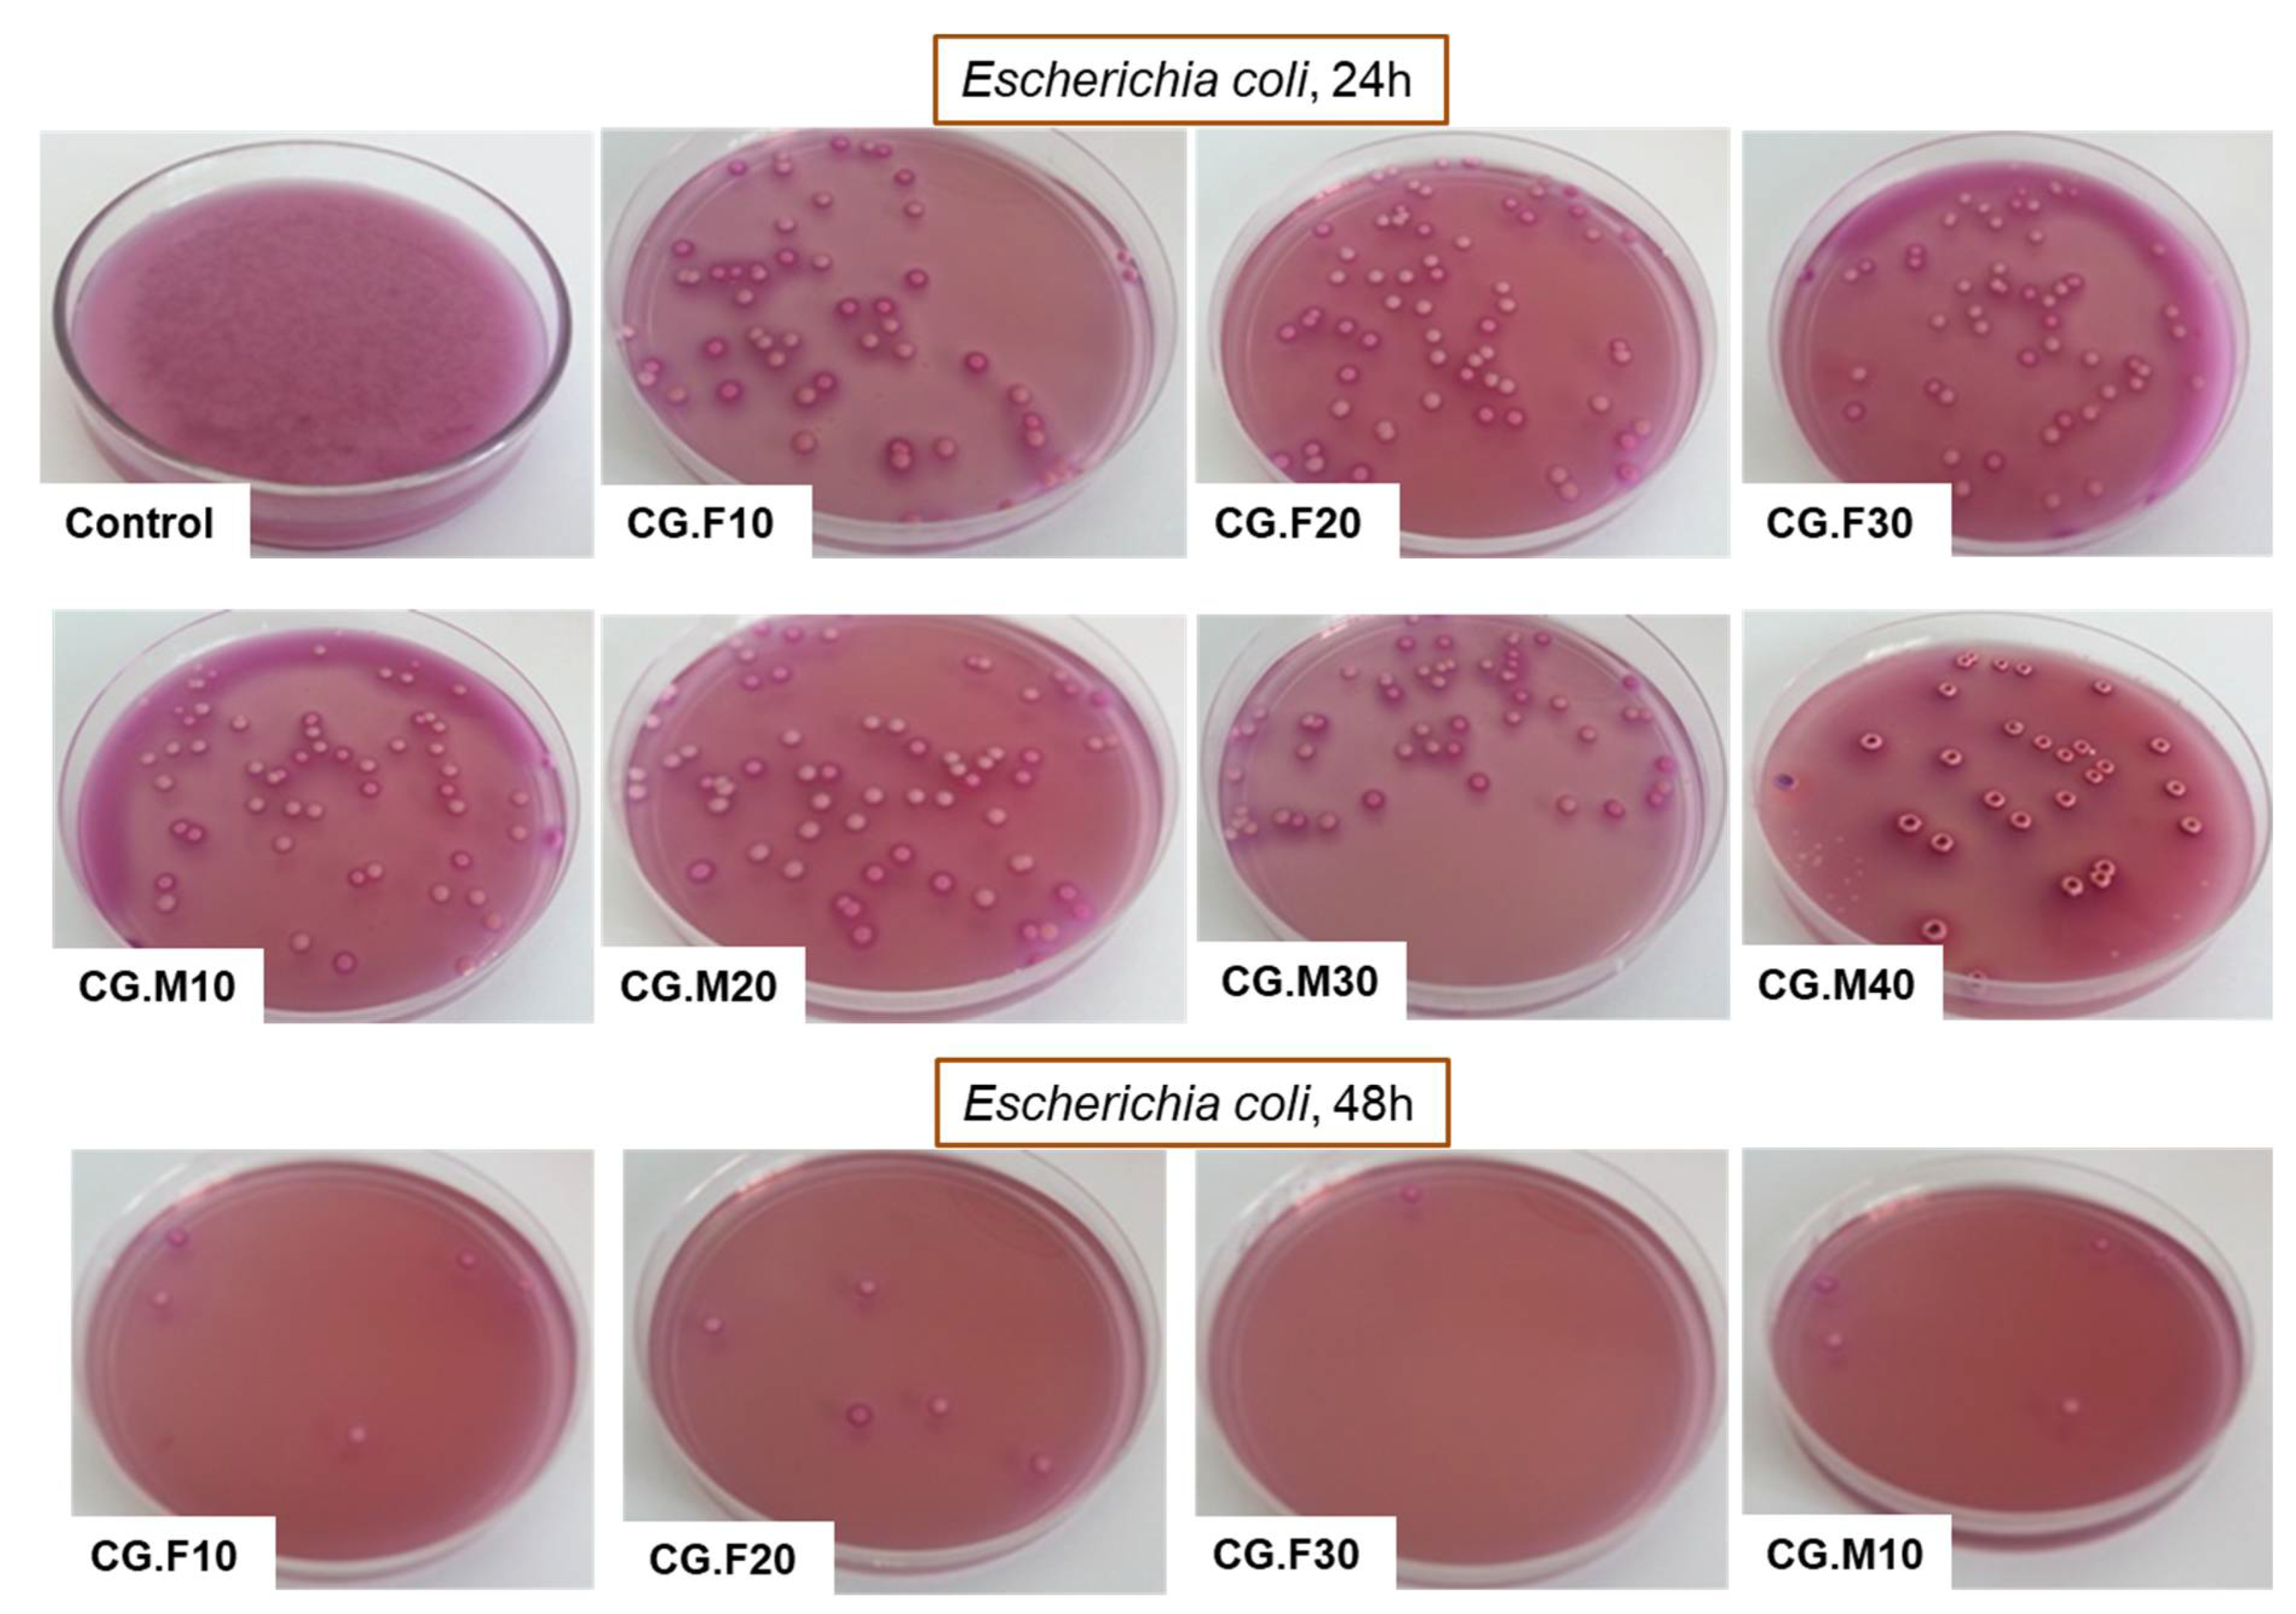
Gels 07 00076 g007 550
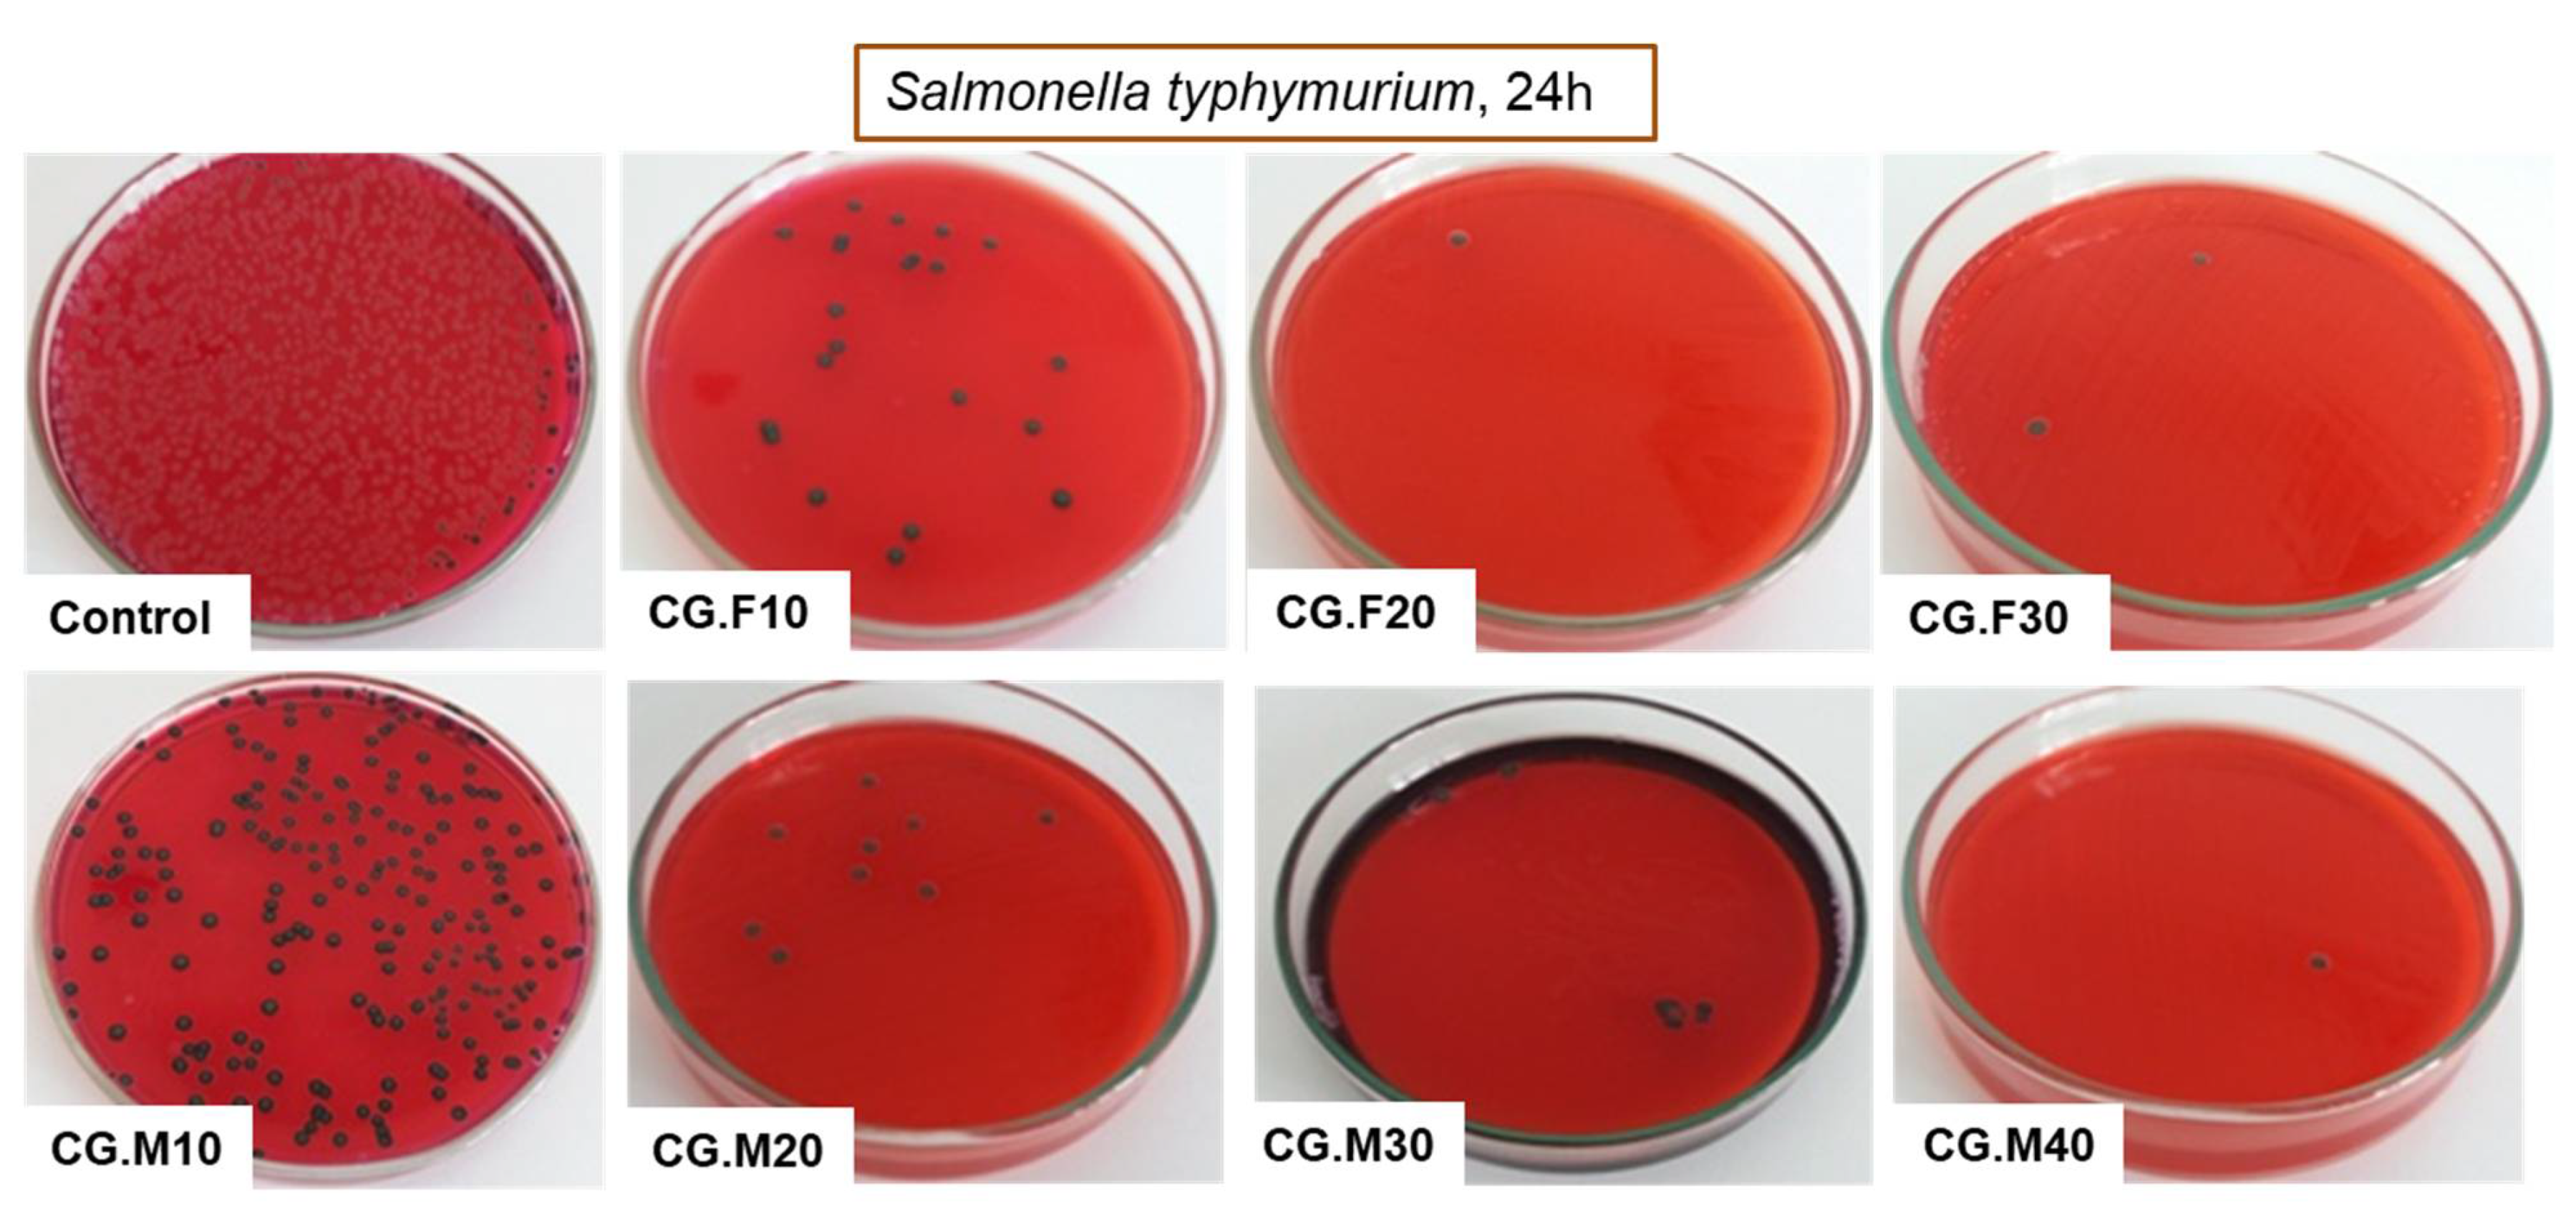
Gels 07 00076 g008 550
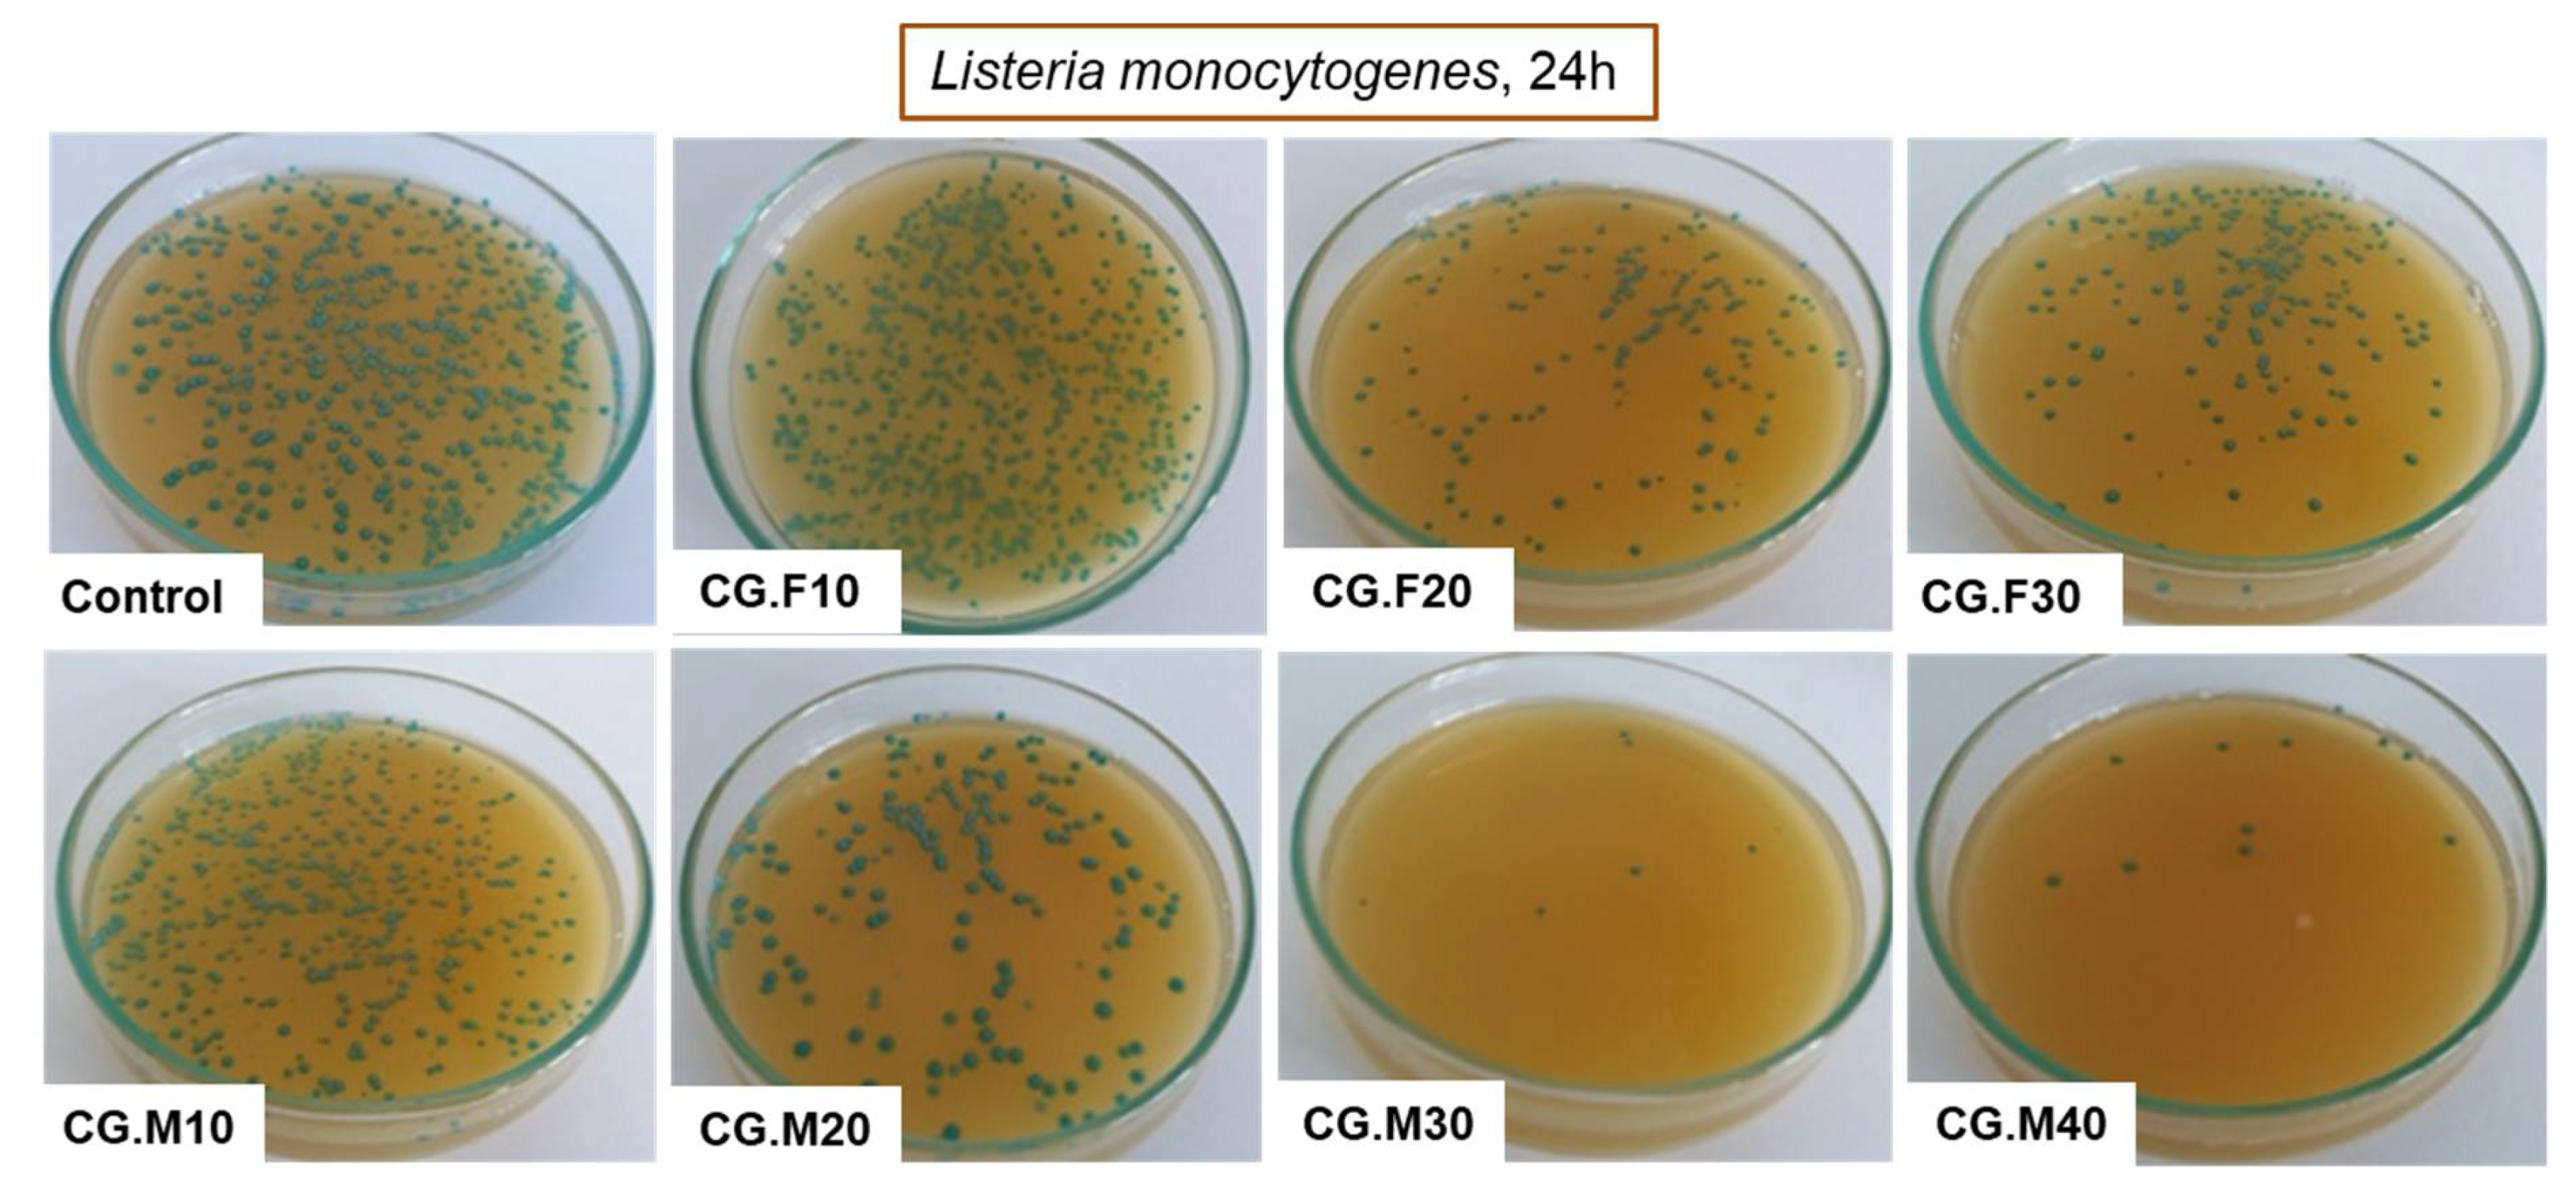
Gels 07 00076 g009 550

A Comparative Analysis on the Effect of Variety of Grape Pomace Extracts on the Ice-Templated 3D Cryogel Features
Abstract
:1. Introduction
2. Results and Discussion
2.1. Preparation and Characterization of Ice-Templated 3D Cryogels
2.2. Effect of Grape Pomace Extracts Type and Their Amount on the Biological Activity of Composites
2.2.1. Antioxidant Activity
2.2.2. Antibacterial Activity
2.3. Effect of Variety of Grape Pomace Extracts and Their Amount on the Texture of Composites
3. Conclusions
4. Materials and Methods
4.1. Materials
4.2. Methods
4.2.1. Preparation of Ice-Templated 3D Cryogels
4.2.2. Gel Permeation Chromatography (GPC)
4.2.3. Water Swelling Analysis
4.2.4. Water Contact Angle Measurements
4.2.5. Morphological and Texture Studies
4.2.6. Elemental Surface Composition
4.2.7. Thermogravimetric (TGA) and Derivative Thermogravimetric (DTG) Analysis
4.2.8. DPPH Radical Scavenging Activity
4.2.9. Testing the Antimicrobial Activity against Gram-Positive and Gram-Negative Microorganisms
Supplementary Materials
Author Contributions
Funding
Institutional Review Board Statement
Informed Consent Statement
Acknowledgments
Conflicts of Interest
References
- Parry, J.W.; Li, H.; Liu, J.-R.; Zhou, K.; Zhang, L.; Ren, S. Antioxidant Activity, Antiproliferation of Colon Cancer Cells, and Chemical Composition of Grape Pomace. Food Sci. Nutr. 2011, 2, 530–540. [Google Scholar] [CrossRef] [Green Version]
- Kafantaris, I.; Kotsampasi, B.; Christodoulou, V.; Kokka, E.; Kouka, P.; Terzopoulou, Z.; Gerasopoulos, K.; Stagos, D.; Mitsagga, C.; Giavasis, I.; et al. Grape pomace improves antioxidant capacity and faecal microflora of lambs. J. Anim. Physiol. Anim. Nutr. 2017, 101, 108–121. [Google Scholar] [CrossRef] [PubMed]
- Garrido, M.D.; Auqui, S.M.; Marti, N.; Linares, M.B. Effect of two different red grape pomace extracts obtained under different extraction systems on meat quality of pork burgers. LWT Food Sci. Technol 2011, 44, 2238–2243. [Google Scholar] [CrossRef]
- Tseng, A.; Yhao, Z. Wine grape pomace as antioxidant dietary fibre for enhancing nutritional value and improving storability of yogurt and salad dressing. Food Chem. 2013, 138, 356–365. [Google Scholar] [CrossRef] [PubMed]
- Persin, Z.; Stana-Kleinschek, K.; Foster, T.J.; van Dam, J.E.G.; Boeriu, C.G.; Navard, P. Challenges and opportunities in polysaccharides research and technology: The EPNOE views for the next decade in the areas of materials, food and health care. Carbohydr. Polym. 2011, 84, 22–32. [Google Scholar] [CrossRef] [Green Version]
- Tharanathan, R.N. Biodegradable films and composite coatings: Past, present and future. Trends Food Sci. Technol. 2003, 14, 71–78. [Google Scholar] [CrossRef]
- Cazon, P.; Velazquez, G.; Ramirez, J.A.; Vazquez, M. Polysaccharide-based films and coatings for food packaging: A review. Food Hydrocoll. 2017, 68, 136–148. [Google Scholar] [CrossRef]
- Dutta, P.K.; Tripathi, S.; Mehrotra, G.K.; Joydeep, D. Perspectives for chitosan based antimicrobial films in food applications. Food Chem. 2009, 114, 1173–1182. [Google Scholar] [CrossRef]
- Espitia, P.J.P.; Du, W.-X.; Avena-Bustillos, R.; Soares, N.; Mchugh, T. Edible films from pectin: Physical-mechanical and antimicrobial properties—A review. Food Hydrocoll. 2014, 35, 287–296. [Google Scholar] [CrossRef]
- Halász, K.; Csóka, L. Black chokeberry (Aronia melanocarpa) pomace extract immobilized in chitosan for colorimetric pH indicator film application. Food Packag. Shelf Life 2018, 16, 185–193. [Google Scholar] [CrossRef]
- Jing, Y.; Diao, Y.; Yu, X. Free radical-mediated conjugation of chitosan withtannic acid: Characterization and antioxidant capacity. React. Funct. Polym. 2019, 135, 16–22. [Google Scholar] [CrossRef]
- Narasagoudr, S.S.; Hegde, V.G.; Chougale, R.B.; Masti, S.P.; Vootla, S.; Malabadi, R.B. Physico-chemical and functional properties of rutin induced chitosan/poly (vinyl alcohol) bioactive films for food packaging applications. Food Hydrocoll. 2020, 109, 106096. [Google Scholar] [CrossRef]
- Riaz, A.; Lei, S.; Akhtar, H.M.S.; Wan, P.; Chen, D.; Jabbar, S.; Abid, M.; Hashim, M.M.; Zeng, X. Preparation and characterization of chitosan-based antimicrobial active food packaging film incorporated with apple peel polyphenols. Int. J. Biol. Macromol. 2018, 114, 547–555. [Google Scholar] [CrossRef]
- Sogut, E.; Seydim, A.C. The effects of chitosan and grape seed extract-based edible films on the quality of vacuum packaged chicken breast fillets. Food Packag. Shelf Life 2018, 18, 13–20. [Google Scholar] [CrossRef]
- Vadivel, M.; Sankarganesh, M.; Raja, J.D.; Rajesh, J.; Mohanasundaram, D.; Alagaret, M. Bioactive constituents and bio-waste derived chitosan/xylan based biodegradable hybrid nanocomposite for sensitive detection of fish freshness. Food Packag. Shelf Life 2019, 22, 100384. [Google Scholar] [CrossRef]
- Golly, M.K.; Ma, H.; Sarpong, F.; Dotse, B.P.; Oteng-Darko, P.; Dong, Y. Shelf-life extension of grape (pinot noir) by xanthan gum enriched with ascorbic and citric acid during cold temperature storage. J. Food Sci. Technol. 2019, 56, 4867–4878. [Google Scholar] [CrossRef] [PubMed]
- Sharma, S.; Rao, R.T.V. Xanthan gum based edible coating enrichedwith cinnamic acid prevents browning and extends the shelf-life of fresh-cut pears. LWT Food Sci. Technol. 2015, 62, 791–800. [Google Scholar] [CrossRef]
- Outukia, P.M.; Belloto de Franciscoa, L.M.; Hoscheid, J.; Bonifácio, K.L.; Barbosa, D.S.; Cardoso, M.L.C. Development ofarabic and xanthan gum microparticles loaded with an extract of Eschweilera nana Miers leaves with antioxidant capacity. Coll Surf. A Physicochem. Eng. Aspects 2016, 499, 103–112. [Google Scholar] [CrossRef]
- Galindo-Pérez, M.J.; Quintanar-Guerrero, D.; Mercado-Silva, E.; Real-Sandoval, S.A.; Zambrano-Zaragoza, M.L. The effects of tocopherol nanocapsules/xanthan gum coatings on the preservation of fresh-cut apples: Evaluation of phenol metabolism. Food Bioprocess Tech. 2015, 8, 1791–1799. [Google Scholar] [CrossRef]
- Mohanty, A.K.; Misra, M.; Hinrichsen, G. Biofibres, biodegradable polymers and biocomposites: An overview. Macromol. Mater. Eng. 2000, 276, 1439–2054. [Google Scholar] [CrossRef]
- Muthuraj, R.; Misra, M.; Mohanty, A.K. Biodegradable compatibilized polymer blends for packaging applications: A literature review. J. Appl. Polym. Sci. 2017, 135, 45726. [Google Scholar] [CrossRef] [Green Version]
- Chattopadhyay, S.K.; Khandal, R.K.; Uppaluri, R.; Aloke, K.G. Ghoshal Bamboo fiber reinforced polypropylene composites and their mechanical, thermal, and morphological properties. J. Appl. Polym. Sci. 2010, 119, 1619–1626. [Google Scholar] [CrossRef]
- Anghel, N.; Dinu, M.V.; Zaltariov, M.; Pamfil, D.; Spiridon, I. New cellulose-collagen-alginate materials incorporated with quercetin, anthocyanins and lipoic acid. Int. J. Biol. Macromol. 2021, 181, 30–40. [Google Scholar] [CrossRef] [PubMed]
- Spiridon, I.; Anghel, N.; Dinu, M.V.; Vlad, S.; Bele, A.; Ciubotaru, B.I.; Verestiuc, L.; Pamfil, D. Development and performance of bioactive compounds-loaded cellulose/collagen/ polyurethane materials. Polymers 2020, 12, 1191. [Google Scholar] [CrossRef] [PubMed]
- Benitez, J.J.; Castillo, P.M.; del Rio, J.C.; Leon-Camacho, M.; Dominiguez, E.; Heredia, A.; Guzman-Puyol, S.; Athanassiou, A.; Heredia-Guerrero, J.A. Valorization of tomato processing by-products: Fatty acid extraction and production of bio-based materials. Materials 2018, 11, 2211. [Google Scholar] [CrossRef] [Green Version]
- Tedeschi, G.; Benitez, J.J.; Ceseracciu, L.; Dastmalchi, K.; Itin, B.; Stark, R.E.; Heredia, A.; Athanassiou, A.; Heredia-Guerrero, J.A. Sustainable fabrication of plant cuticle-like packaging films from tomato pomace agro-waste, beeswax, and alginate. ACS Sustain. Chem. Eng. 2018, 6, 14955–14966. [Google Scholar] [CrossRef]
- Raschip, I.E.; Fifere, N.; Varganici, C.D.; Dinu, M.V. Development of antioxidant andantimicrobial xanthan-based cryogels with tuned porous morphology and controlled swelling features. Int. J. Biol. Macromol. 2020, 156, 608–620. [Google Scholar] [CrossRef]
- Raschip, I.E.; Dinu, M.V.; Fifere, N.; Darie-Nita, R.; Pamfil, D.; Popirda, A.; Logigan, C. Thermal, mechanical and water sorption properties of xanthan-based composite cryogels. Cellul. Chem. Technol. 2020, 54, 915–924. [Google Scholar] [CrossRef]
- Vogler, E.A. Structure and reactivity of water at biomaterial surfaces. Adv. Colloid Interface Sci. 1998, 74, 69–117. [Google Scholar] [CrossRef]
- Rambabu, K.; Bharath, G.; Banat, F.; Show, P.L.; Cocoletzi, H.H. Mango leaf extract incorporated chitosan antioxidant film for active food packaging. Int. J. Biol. Macromol. 2019, 126, 1234–1243. [Google Scholar]
- Luchian, C.E.; Cotea, V.V.; Vlase, L.; Toiu, A.M.; Colibaba, L.C.; Răschip, I.E.; Nadăș, G.; Gheldiu, A.M.; Tuchiluș, C.; Rotaru, L. Antioxidant and antimicrobial effects of grape pomace extracts. In Proceedings of the 42nd World Congress of Vine and Wine, Les Ulis, France, 15–19 July 2019; Volume 15, p. 04006. [Google Scholar] [CrossRef]
- Bi, F.; Yong, H.; Jing Liu, J.; Zhang, X.; Shu, Y.; Liu, J. Development and characterization of chitosan and D-α-tocopheryl polyethylene glycol 1000 succinate composite films containing different flavones. Food Packag. Shelf Life 2020, 25, 100531. [Google Scholar] [CrossRef]
- Ferreira, A.S.; Nunes, C.; Castro, A.; Ferreira, P.; Coimbra, M.A. Influence of grape pomace extract incorporation on chitosan films properties. Carbohydr. Polym. 2014, 113, 490–499. [Google Scholar] [CrossRef] [PubMed]
- Bi, F.; Zhang, X.; Bai, R.; Liu, Y.; Liu, J.; Liu, J. Preparation and characterization of antioxidant and antimicrobial packaging films based on chitosan and proanthocyanidins. Int. J. Biol. Macromol. 2019, 134, 11–19. [Google Scholar] [CrossRef]
- Ahvenainen, R. Active and intelligent packaging: An introduction. In Novel Food Packaging Techniques; Ahvenainen, R., Ed.; Woodhead Publishing: Cambridge, UK, 2003; pp. 5–21. [Google Scholar]
- Bozic, M.; Gorgieva, S.; Kokol, V. Homogeneous and heterogeneous methods for laccase-mediated functionalization of chitosan by tannic acid and quercetin. Carbohydr. Polym. 2012, 89, 854–864. [Google Scholar] [CrossRef] [PubMed]
- Sheet, S.; Vinothkannan, M.; Balasubramaniam, S.; Subramaniyan, S.A.; Acharya, S.; Lee, Y.S. Highly flexible electrospun hybrid (polyurethane/dextran/pyocyanin) membrane for antibacterial activity via generation of oxidative stress. ACS Omega 2018, 3, 14551–14561. [Google Scholar] [CrossRef] [Green Version]
- Field, J.A.; Lettinga, G. Toxicity of Tannic Compounds to Microorganisms; Hemingway, R.W., Laks, P.E., Eds.; Basic Life Sciences: New York, NY, USA, 1992; pp. 673–692. [Google Scholar]
- Yong, H.; Bi, F.; Liu, J.; Qin, Y.; Bai, R.; Liu, J. Preparation and characterization of antioxidant packaging by chitosan, D-α-tocopheryl polyethylene glycol 1000 succinate and baicalein. Int. J. Biol. Macromol. 2020, 153, 836–845. [Google Scholar] [CrossRef]
- Pelletier, E.; Viebke, C.; Meadows, J.; Williams, P.A.A. Rheological study of the order–disorder conformational transition of xanthan gum. Biopolymers 2001, 59, 339–346. [Google Scholar] [CrossRef]
- Sloneker, J.H.; Orentas, D.G. Pyruvic acid, a unique component of an exocellular bacterial polysaccharide. Nature 1962, 194, 478–479. [Google Scholar] [CrossRef] [PubMed]
- Luchian, C.E.; Scutarasu, E.C.; Colibaba, L.C.; Cotea, V.V.; Vlase, L.; Toiu, A.M. Evaluation of byproducts from the wine-making industry by identification of bioactive compounds. In Proceedings of the 41st World Congress of Vine and Wine, Les Ulis, France, 15–19 July 2019; Volume 12, p. 04007. [Google Scholar] [CrossRef]
- Raschip, I.E.; Paduraru-Mocanu, O.M.; Nita, L.E.; Dinu, M.V. Antibacterial porous xanthan-based films containing flavoring agents evaluated by near infrared chemical imaging technique. J. Appl. Polym. Sci. 2020, 137, e49111. [Google Scholar] [CrossRef]
- Dinu, M.V.; Lazar, M.M.; Dragan, E.S. Dual ionic cross-linked alginate/clinoptilolite composite microbeads with improved stability and enhanced sorption properties for methylene blue. React. Funct. Polym. 2017, 116, 31–40. [Google Scholar] [CrossRef]

| Samples a | XG, wt.% | PVA, wt.% | Amount of Grape Pomace Extracts, v/v% | SR b, g/g |
|---|---|---|---|---|
| CG | 50 | 50 | 0 | 32.14 ± 1.22 |
| CG.F10 | 50 | 50 | 10 | 21.92 ± 2.60 |
| CG.F20 | 50 | 50 | 20 | 20.92 ± 1.71 |
| CG.F30 | 50 | 50 | 30 | 15.80 ± 2.05 |
| CG.M10 | 50 | 50 | 10 | 20.00 ± 0.94 |
| CG.M20 | 50 | 50 | 20 | 16.55 ± 1.14 |
| CG.M30 | 50 | 50 | 30 | 13.25 ± 0.88 |
| CG.M40 | 50 | 50 | 40 | 11.19 ± 1.47 |
| Sample | Stage | Tonset (°C) | Tmax (°C) | Tendset (°C) | Wm (%) | Wrez (%) |
|---|---|---|---|---|---|---|
| CG | I | 38 | 79 | 112 | 19.96 | |
| II | 237 | 301 | 330 | 56.56 | ||
| III | 377 | 434 | 479 | 14.17 | 18.3 | |
| CG.F10 | I | 42 | 64 | 101 | 6.53 | |
| II | 171 | 203 | 235 | 24.75 | ||
| III | 262 | 296 | 345 | 24.75 | ||
| IV | 345 | 440 | 481 | 13.54 | 28.9 |
| Sample | Inhibition (%) Escherichia coli | Inhibition (%) Salmonella typhymurium | Inhibition (%) Listeria monocytogenes | |
|---|---|---|---|---|
| 24 h | 48 h | 24 h | 24 h | |
| Control | 0 | 0 | 0 | 0 |
| CG | 35 | - | 26 | 77 |
| CG.F10 | 66 | 18 | 86 | 18 |
| CG.F20 | 68 | 22 | 94 | 22 |
| CG.F30 | 76 | 41 | 95 | 41 |
| CG.M10 | 75 | 67 | 43 | 67 |
| CG.M20 | 74 | 71 | 99 | 71 |
| CG.M30 | 71 | 96 | 99 | 96 |
| CG.M40 | 86 | 93 | 99 | 93 |
| Samples | PVA | XG | CG | CG.F10 | CG.F20 | CG.F30 | CG.M10 | CG.M20 | CG.M30 | CG.M40 |
|---|---|---|---|---|---|---|---|---|---|---|
| Pore sizes, µm | 138 ± 25 | 125 ± 22 | 117 ± 22 | 114 ± 12 | 72 ± 11 | 137 ± 21 | 103 ± 17 | 86 ± 6 | 60 ± 8 | 90 ± 12 |
Publisher’s Note: MDPI stays neutral with regard to jurisdictional claims in published maps and institutional affiliations. |
© 2021 by the authors. Licensee MDPI, Basel, Switzerland. This article is an open access article distributed under the terms and conditions of the Creative Commons Attribution (CC BY) license (https://creativecommons.org/licenses/by/4.0/).
Share and Cite
Raschip, I.E.; Fifere, N.; Dinu, M.V. A Comparative Analysis on the Effect of Variety of Grape Pomace Extracts on the Ice-Templated 3D Cryogel Features. Gels 2021, 7, 76. https://doi.org/10.3390/gels7030076
Raschip IE, Fifere N, Dinu MV. A Comparative Analysis on the Effect of Variety of Grape Pomace Extracts on the Ice-Templated 3D Cryogel Features. Gels. 2021; 7(3):76. https://doi.org/10.3390/gels7030076
Chicago/Turabian StyleRaschip, Irina Elena, Nicusor Fifere, and Maria Valentina Dinu. 2021. "A Comparative Analysis on the Effect of Variety of Grape Pomace Extracts on the Ice-Templated 3D Cryogel Features" Gels 7, no. 3: 76. https://doi.org/10.3390/gels7030076
APA StyleRaschip, I. E., Fifere, N., & Dinu, M. V. (2021). A Comparative Analysis on the Effect of Variety of Grape Pomace Extracts on the Ice-Templated 3D Cryogel Features. Gels, 7(3), 76. https://doi.org/10.3390/gels7030076

